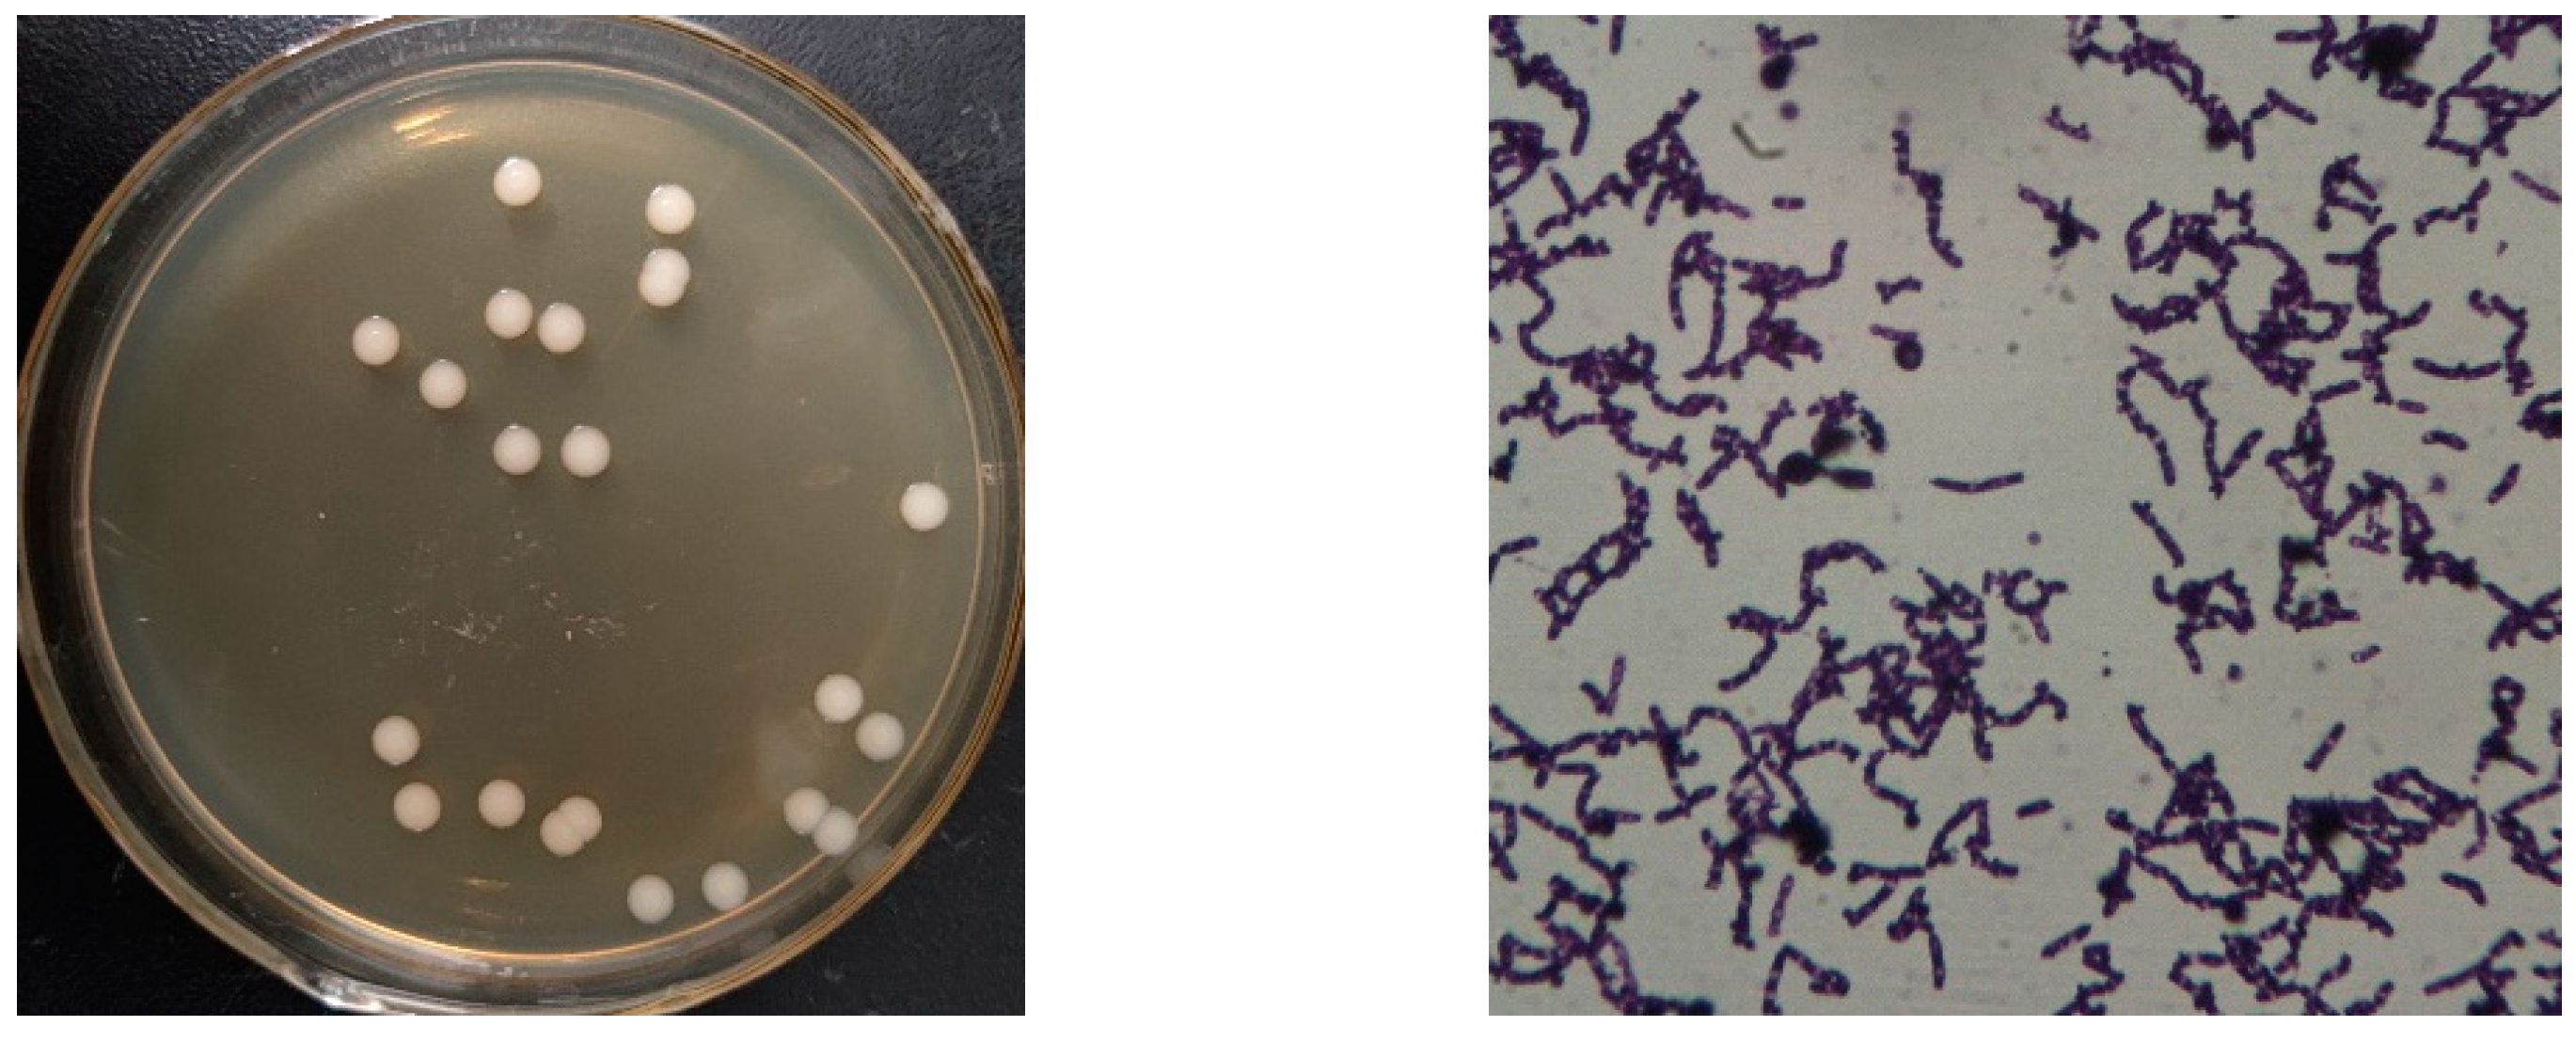

Biodegradation of Uric Acid by Bacillus paramycoides-YC02
Abstract
1. Introduction
2. Materials and Methods
2.1. Samples and Mediums
2.2. Isolation of UA Biodegrading Bacteria
2.3. Identification and Draft Genome Sequencing of YC02
2.4. Optimization of UA Biodegradation Conditions
2.5. Biodegradation of UA by CE of YC02
2.6. Analysis of UA by HPLC
3. Results and Discussion
3.1. Isolation and Identification of UA Biodegrading Strain
3.2. Effects of Culture Conditions on Biodegradation of UA by YC02
3.3. Biodegradation of UA by B. Paramycoides-YC02 and Its CE
3.4. Genomic Analysis and Metabolism Pathway for UA Biodegradation
4. Conclusions
Author Contributions
Funding
Data Availability Statement
Conflicts of Interest
References
- Wang, Q.; Wen, X.; Kong, J. Recent Progress on Uric Acid Detection: A Review. Crit. Rev. Anal. Chem. 2020, 50, 359–375. [Google Scholar] [CrossRef] [PubMed]
- Ruiz, A.; Gautschi, I.; Schild, L.; Bonny, O. Human Mutations in SLC2A9 (Glut9) Affect Transport Capacity for Urate. Front. Physiol. 2018, 9, 476. [Google Scholar] [CrossRef]
- Maiuolo, J.; Oppedisano, F.; Gratteri, S.; Muscoli, C.; Mollace, V. Regulation of uric acid metabolism and excretion. Int. J. Cardiol. 2016, 213, 8–14. [Google Scholar] [CrossRef]
- Qin, N.; Qin, M.; Shi, W.; Kong, L.; Wang, L.; Xu, G.; Guo, Y.; Zhang, J.; Ma, Q. Investigation of pathogenesis of hyperuricemia based on untargeted and targeted metabolomics. Sci. Rep. 2022, 12, 13980. [Google Scholar] [CrossRef]
- Piao, W.; Zhao, L.; Yang, Y.; Fang, H.; Ju, L.; Cai, S.; Yu, D. The Prevalence of Hyperuricemia and Its Correlates among Adults in China: Results from CNHS 2015–2017. Nutrients 2022, 14, 4095. [Google Scholar] [CrossRef] [PubMed]
- Huang, J.; Ma, Z.F.; Zhang, Y.; Wan, Z.; Li, Y.; Zhou, H.; Chu, A.; Lee, Y.Y. Geographical distribution of hyperuricemia in mainland China: A comprehensive systematic review and meta-analysis. Glob. Health Res. Policy 2020, 5, 52. [Google Scholar] [CrossRef] [PubMed]
- Chen-Xu, M.; Yokose, C.; Rai, S.K.; Pillinger, M.H.; Choi, H.K. Contemporary Prevalence of Gout and Hyperuricemia in the United States and Decadal Trends: The National Health and Nutrition Examination Survey, 2007–2016. Arthritis Rheumatol. 2019, 71, 991–999. [Google Scholar] [CrossRef]
- Vedder, D.; Walrabenstein, W.; Heslinga, M.; de Vries, R.; Nurmohamed, M.; van Schaardenburg, D.; Gerritsen, M. Dietary Interventions for Gout and Effect on Cardiovascular Risk Factors: A Systematic Review. Nutrients 2019, 11, 2955. [Google Scholar] [CrossRef]
- Kuma, A.; Kato, A. Lifestyle-Related Risk Factors for the Incidence and Progression of Chronic Kidney Disease in the Healthy Young and Middle-Aged Population. Nutrients 2022, 14, 3787. [Google Scholar] [CrossRef]
- Li, L.; Zhao, M.; Wang, C.; Zhang, S.; Yun, C.; Chen, S.; Cui, L.; Wu, S.; Xue, H. Early onset of hyperuricemia is associated with increased cardiovascular disease and mortality risk. Clin. Res. Cardiol. 2021, 110, 1096–1105. [Google Scholar] [CrossRef]
- Mancia, G.; Grassi, G.; Borghi, C. Hyperuricemia, urate deposition and the association with hypertension. Curr. Med. Res. Opin. 2015, 31, 15–19. [Google Scholar] [CrossRef] [PubMed]
- Mortada, I. Hyperuricemia, Type 2 Diabetes Mellitus, and Hypertension: An Emerging Association. Curr. Hypertens. Rep. 2017, 19, 69. [Google Scholar] [CrossRef]
- Lee, M.J.; Khang, A.R.; Kang, Y.H.; Yun, M.S.; Yi, D. Synergistic Interaction between Hyperuricemia and Abdominal Obesity as a Risk Factor for Metabolic Syndrome Components in Korean Population. Diabetes Metab. J. 2022, 46, 756–766. [Google Scholar] [CrossRef]
- Fang, G.; Li, W.; Zhang, J.; Ke, Q.; Zhu, X.; Long, L.; Li, C. Safety and tolerability of available drugs for hyperuricemia: A critical review and an update on recent developments. J. Chin. Pharm. Sci. 2022, 31, 397–411. [Google Scholar] [CrossRef]
- Strilchuk, L.; Fogacci, F.; Cicero, A.F. Safety and tolerability of available urate-lowering drugs: A critical review. Expert Opin. Drug Saf. 2019, 18, 261–271. [Google Scholar] [CrossRef]
- Lee, M.H.; Graham, G.G.; Williams, K.M.; Day, R.O. A benefit-risk assessment of benzbromarone in the treatment of gout. Was its withdrawal from the market in the best interest of patients? Drug Saf. 2008, 31, 643–665. [Google Scholar] [CrossRef]
- Keenan, R.T. Safety of urate-lowering therapies: Managing the risks to gain the benefits. Rheum. Dis. Clin. N. Am. 2012, 38, 663–680. [Google Scholar] [CrossRef] [PubMed]
- Shahid, H.; Singh, J.A. Investigational drugs for hyperuricemia. Expert Opin. Investig. Drugs 2015, 24, 1013–1030. [Google Scholar] [CrossRef] [PubMed]
- Xu, H.; Wu, J.; Wang, S.; Xu, L.; Liu, P.; Shi, Y.; Wu, S.; Deng, L.; Chen, X. Network pharmacology and in vivo experiments reveal the pharmacological effects and molecular mechanisms of Simiao Powder in prevention and treatment for gout. BMC Complement. Med. Ther. 2022, 22, 152. [Google Scholar] [CrossRef]
- Liu, Y.W.; Sun, W.F.; Zhang, X.X.; Li, J.; Zhang, H.H. Compound Tufuling Granules ([characters: See text]) regulate glucose transporter 9 expression in kidney to influence serum uric acid level in hyperuricemia mice. Chin. J. Integr. Med. 2015, 21, 823–829. [Google Scholar] [CrossRef]
- Lu, R.; Chen, J.; Liu, B.; Lin, H.; Bai, L.; Zhang, P.; Chen, D.; Li, H.; Li, J.; Pang, Y.; et al. Protective role of Astragaloside IV in chronic glomerulonephritis by activating autophagy through PI3K/AKT/AS160 pathway. Phytother. Res. 2020, 34, 3236–3248. [Google Scholar] [CrossRef] [PubMed]
- Sun, Z.; Li, Z.; Tan, Y.; Wang, X.; Wang, C.; Dong, M.; Liu, H.; Chen, H.; Li, Y.; Li, L.; et al. Anti-Gouty Arthritis and Anti-Hyperuricemia Properties of Sanghuangporus vaninii and Inonotus hispidus in Rodent Models. Nutrients 2022, 14, 4421. [Google Scholar] [CrossRef] [PubMed]
- Chen, L.; Luo, Z.; Wang, M.; Cheng, J.; Li, F.; Lu, H.; He, Q.; You, Y.; Zhou, X.; Kwan, H.Y.; et al. The Efficacy and Mechanism of Chinese Herbal Medicines in Lowering Serum Uric Acid Levels: A Systematic Review. Front. Pharmacol. 2020, 11, 578318. [Google Scholar] [CrossRef] [PubMed]
- Yue, S.J.; Wang, W.X.; Yu, J.G.; Chen, Y.Y.; Shi, X.Q.; Yan, D.; Zhou, G.S.; Zhang, L.; Wang, C.Y.; Duan, J.A.; et al. Gut microbiota modulation with traditional Chinese medicine: A system biology-driven approach. Pharmacol. Res. 2019, 148, 104453. [Google Scholar] [CrossRef] [PubMed]
- Lin, J.; Chen, S.; Li, S.; Lu, M.; Li, Y.; Su, Y. Efficacy and Safety of Chinese Medicinal Herbs for the Treatment of Hyperuricemia: A Systematic Review and Meta-Analysis. Evid. Based Complement. Altern. Med. 2016, 2016, 2146204. [Google Scholar] [CrossRef] [PubMed]
- Kakutani-Hatayama, M.; Kadoya, M.; Okazaki, H.; Kurajoh, M.; Shoji, T.; Koyama, H.; Tsutsumi, Z.; Moriwaki, Y.; Namba, M.; Yamamoto, T. Nonpharmacological Management of Gout and Hyperuricemia: Hints for Better Lifestyle. Am. J. Lifestyle Med. 2017, 11, 321–329. [Google Scholar] [CrossRef]
- Ebrahimpour-Koujan, S.; Saneei, P.; Larijani, B.; Esmaillzadeh, A. Consumption of sugar sweetened beverages and dietary fructose in relation to risk of gout and hyperuricemia: A systematic review and meta-analysis. Crit. Rev. Food Sci. Nutr. 2020, 60, 1–10. [Google Scholar] [CrossRef]
- Sun, L.; Ni, C.; Zhao, J.; Wang, G.; Chen, W. Probiotics, bioactive compounds and dietary patterns for the effective management of hyperuricemia: A review. Crit. Rev. Food Sci. Nutr. 2022, 1–16. [Google Scholar] [CrossRef]
- Cao, J.; Bu, Y.; Hao, H.; Liu, Q.; Wang, T.; Liu, Y.; Yi, H. Effect and Potential Mechanism of Lactobacillus plantarum Q7 on Hyperuricemia in vitro and in vivo. Front. Nutr. 2022, 9, 954545. [Google Scholar] [CrossRef]
- Wu, Y.; Ye, Z.; Feng, P.; Li, R.; Chen, X.; Tian, X.; Han, R.; Kakade, A.; Liu, P.; Li, X. Limosilactobacillus fermentum JL-3 isolated from “Jiangshui” ameliorates hyperuricemia by degrading uric acid. Gut Microbes 2021, 13, 1897211. [Google Scholar] [CrossRef]
- Kuo, Y.W.; Hsieh, S.H.; Chen, J.F.; Liu, C.R.; Chen, C.W.; Huang, Y.F.; Ho, H.H. Lactobacillus reuteri TSR332 and Lactobacillus fermentum TSF331 stabilize serum uric acid levels and prevent hyperuricemia in rats. PeerJ 2021, 9, e11209. [Google Scholar] [CrossRef] [PubMed]
- Ni, C.; Li, X.; Wang, L.; Li, X.; Zhao, J.; Zhang, H.; Wang, G.; Chen, W. Lactic acid bacteria strains relieve hyperuricaemia by suppressing xanthine oxidase activity via a short-chain fatty acid-dependent mechanism. Food Funct. 2021, 12, 7054–7067. [Google Scholar] [CrossRef] [PubMed]
- Tripathi, S.; Parmar, J.; Kumar, A. Structure-Based Immunogenicity Prediction of Uricase from Fungal (Aspergillus flavus), Bacterial (Bacillus subtillis) and Mammalian Sources Using Immunoinformatic Approach. Protein J. 2020, 39, 133–144. [Google Scholar] [CrossRef] [PubMed]
- Pawar, S.V.; Rathod, V.K. Ultrasound assisted process intensification of uricase and alkaline protease enzyme co-production in Bacillus licheniformis. Ultrason. Sonochem. 2018, 45, 173–179. [Google Scholar] [CrossRef] [PubMed]
- Lotfy, W.A. Production of a thermostable uricase by a novel Bacillus thermocatenulatus strain. Bioresour. Technol. 2008, 99, 699–702. [Google Scholar] [CrossRef]
- Khade, S.; Srivastava, S.K. Effect of surfactants and inducers on increased uricase production under submerged fermentations by Bacillus cereus. Prep. Biochem. Biotechnol. 2017, 47, 81–85. [Google Scholar] [CrossRef]
- Zhao, Z.; Liu, C.; Xu, Q.; Ahmad, S.; Zhang, H.; Pang, Y.; Aikemu, A.; Liu, Y.; Yan, H. Characterization and genomic analysis of an efficient dibutyl phthalate degrading bacterium Microbacterium sp. USTB-Y. World J. Microbiol. Biotechnol. 2021, 37, 212. [Google Scholar] [CrossRef]
- Li, M.; Yang, D.; Mei, L.; Yuan, L.; Xie, A.; Yuan, J. Screening and characterization of purine nucleoside degrading lactic acid bacteria isolated from Chinese sauerkraut and evaluation of the serum uric acid lowering effect in hyperuricemic rats. PLoS ONE 2014, 9, e105577. [Google Scholar] [CrossRef]
- Liu, C.; Xu, Q.; Zhao, Z.; Zhang, H.; Liu, X.; Yin, C.; Liu, Y.; Yan, H. Genomic Analysis of Sphingopyxis sp. USTB-05 for Biodegrading Cyanobacterial Hepatotoxins. Toxins 2022, 14, 333. [Google Scholar] [CrossRef]
- Zhang, M.; Pan, G.; Yan, H. Microbial biodegradation of microcystin-RR by bacterium Sphingopyxis sp. USTB-05. J. Environ. Sci. 2010, 22, 168–175. [Google Scholar] [CrossRef]
- Lee, Y.; Kim, N.; Werlinger, P.; Suh, D.A.; Lee, H.; Cho, J.H.; Cheng, J. Probiotic Characterization of Lactobacillus brevis MJM60390 and In Vivo Assessment of Its Antihyperuricemic Activity. J. Med. Food 2022, 25, 367–380. [Google Scholar] [CrossRef] [PubMed]
- Smith, D.L.; Lemieux, E.N.; Barua, S. Correction in Bicinchoninic Acid (BCA) Absorbance Assay to Analyze Protein Concentration. Nano LIFE 2018, 8, 1850005. [Google Scholar] [CrossRef]
- Yamada, N.; Saito-Iwamoto, C.; Nakamura, M.; Soeda, M.; Chiba, Y.; Kano, H.; Asami, Y. Lactobacillus gasseri PA-3 Uses the Purines IMP, Inosine and Hypoxanthine and Reduces their Absorption in Rats. Microorganisms 2017, 5, 10. [Google Scholar] [CrossRef] [PubMed]
- Liu, Y.; Du, J.; Lai, Q.; Zeng, R.; Ye, D.; Xu, J.; Shao, Z. Proposal of nine novel species of the Bacillus cereus group. Int. J. Syst. Evol. Microbiol. 2017, 67, 2499–2508. [Google Scholar] [CrossRef] [PubMed]
- Ren, J.; Wang, C.; Huhetaoli; Li, C.; Fan, B.; Niu, D. Biodegradation of acephate by Bacillus paramycoides NDZ and its degradation pathway. World J. Microbiol. Biotechnol. 2020, 36, 155. [Google Scholar] [CrossRef] [PubMed]
- Wu, H.; Liu, Q.; Sun, W.; Lu, Y.; Qi, Y.; Zhang, H. Biodegradability of polyethylene mulch film by Bacillus paramycoides. Chemosphere 2022, 311, 136978. [Google Scholar] [CrossRef]
- Hallol, M.; Helmy, O.; Shawky, A.-E.; El-Batal, A.; Ramadan, M. Optimization of Alpha-Amylase Production by a Local Bacillus paramycoides Isolate and Immobilization on Chitosan-Loaded Barium Ferrite Nanoparticles. Fermentation 2022, 8, 241. [Google Scholar] [CrossRef]
- Tiwari, S.; Singh, R.; Yadav, J.; Gaur, R.; Singh, A.; Yadav, J.S.; Pandey, P.K.; Yadav, S.K.; Prajapati, J.; Helena, P.; et al. Three-Step Purification and Characterization of Organic Solvent-Tolerant and Alkali-Thermo-Tolerant Xylanase from Bacillus paramycoides T4 [MN370035]. Catalysts 2022, 12, 749. [Google Scholar] [CrossRef]
- Verma, P.; Tripathi, S.; Yadav, S.; Chandra, R. Degradation and decolourization potential of ligninolytic enzyme producing Bacillus paramycoides BL2 and Micrococcus luteus BL3 for pulp paper industrial effluent and its toxicity evaluation. Arch. Microbiol. 2022, 204, 642. [Google Scholar] [CrossRef]
- Singh, A.; Mishra, S.; Choudhary, M.; Chandra, P.; Rai, A.K.; Yadav, R.K.; Chander Sharma, P. Rhizobacteria improve rice zinc nutrition in deficient soils. Rhizosphere 2023, 25, 100646. [Google Scholar] [CrossRef]
- Rashid, A.; Mirza, S.A.; Keating, C.; Ali, S.; Campos, L.C. Hospital wastewater treated with a novel bacterial consortium (Alcaligenes faecalis and Bacillus paramycoides spp.) for phytotoxicity reduction in Berseem clover and tomato crops. Water Sci. Technol. 2021, 83, 1764–1780. [Google Scholar] [CrossRef] [PubMed]
- Wang, J.; Wu, P.; Chen, J.; Yan, H. Biodegradation of Microcystin-RR by a New Isolated Sphingopyxis sp. USTB-05. Chin. J. Chem. Eng. 2010, 18, 108–112. [Google Scholar] [CrossRef]
- Suwannasom, N.; Kao, I.; Pruss, A.; Georgieva, R.; Baumler, H. Riboflavin: The Health Benefits of a Forgotten Natural Vitamin. Int. J. Mol. Sci. 2020, 21, 950. [Google Scholar] [CrossRef]
- O’Leary, S.E.; Hicks, K.A.; Ealick, S.E.; Begley, T.P. Biochemical characterization of the HpxO enzyme from Klebsiella pneumoniae, a novel FAD-dependent urate oxidase. Biochemistry 2009, 48, 3033–3035. [Google Scholar] [CrossRef]
- Kahn, K.; Tipton, P.A. Spectroscopic characterization of intermediates in the urate oxidase reaction. Biochemistry 1998, 37, 11651–11659. [Google Scholar] [CrossRef]
- Wang, H.; Mei, L.; Deng, Y.; Liu, Y.; Wei, X.; Liu, M.; Zhou, J.; Ma, H.; Zheng, P.; Yuan, J.; et al. Lactobacillus brevis DM9218 ameliorates fructose-induced hyperuricemia through inosine degradation and manipulation of intestinal dysbiosis. Nutrition 2019, 62, 63–73. [Google Scholar] [CrossRef] [PubMed]
- Cai, L.; Li, Q.; Deng, Y.; Liu, X.; Du, W.; Jiang, X. Construction and expression of recombinant uricase-expressing genetically engineered bacteria and its application in rat model of hyperuricemia. Int. J. Mol. Med. 2020, 45, 1488–1500. [Google Scholar] [CrossRef] [PubMed]
- Wang, R.; Lin, F.; Ye, C.; Aihemaitijiang, S.; Halimulati, M.; Huang, X.; Jiang, Z.; Li, L.; Zhang, Z. Multi-omics analysis reveals therapeutic effects of Bacillus subtilis-fermented Astragalus membranaceus in hyperuricemia via modulation of gut microbiota. Food Chem. 2023, 399, 133993. [Google Scholar] [CrossRef]
- Chen, M.; Lu, X.; Lu, C.; Shen, N.; Jiang, Y.; Chen, M.; Wu, H. Soluble uric acid increases PDZK1 and ABCG2 expression in human intestinal cell lines via the TLR4-NLRP3 inflammasome and PI3K/Akt signaling pathway. Arthritis Res. Ther. 2018, 20, 20. [Google Scholar] [CrossRef]

| Gene ID | Database | Enzyme |
|---|---|---|
| gene 1530, gene 2198 | KEGG | purine nucleosidase (EC:3.2.2.1) |
| gene 2643, gene 4968 | COG | nucleoside hydrolase |
| gene 3823, gene 4212 | KEGG | 5’-nucleotidase (EC:3.1.3.5) |
| gene 4226 | KEGG | purine-nucleoside phosphorylase (EC:2.4.2.1) |
| gene 2891, gene 5313 | KEGG | hypoxanthine phosphoribosyltransferase (EC:2.4.2.8) |
| gene 0649 | KEGG | xanthine phosphoribosyltransferase (EC:2.4.2.22) |
| gene 3326 | KEGG | adenine phosphoribosyltransferase (EC:2.4.2.7) |
| gene 2775 | KEGG | adenine deaminase (EC:3.5.4.2) |
Disclaimer/Publisher’s Note: The statements, opinions and data contained in all publications are solely those of the individual author(s) and contributor(s) and not of MDPI and/or the editor(s). MDPI and/or the editor(s) disclaim responsibility for any injury to people or property resulting from any ideas, methods, instructions or products referred to in the content. |
© 2023 by the authors. Licensee MDPI, Basel, Switzerland. This article is an open access article distributed under the terms and conditions of the Creative Commons Attribution (CC BY) license (https://creativecommons.org/licenses/by/4.0/).
Share and Cite
Cao, X.; Cai, J.; Zhang, Y.; Liu, C.; Song, M.; Xu, Q.; Liu, Y.; Yan, H. Biodegradation of Uric Acid by Bacillus paramycoides-YC02. Microorganisms 2023, 11, 1989. https://doi.org/10.3390/microorganisms11081989
Cao X, Cai J, Zhang Y, Liu C, Song M, Xu Q, Liu Y, Yan H. Biodegradation of Uric Acid by Bacillus paramycoides-YC02. Microorganisms. 2023; 11(8):1989. https://doi.org/10.3390/microorganisms11081989
Chicago/Turabian StyleCao, Xiaoyu, Jingyuan Cai, Yu Zhang, Chao Liu, Meijie Song, Qianqian Xu, Yang Liu, and Hai Yan. 2023. "Biodegradation of Uric Acid by Bacillus paramycoides-YC02" Microorganisms 11, no. 8: 1989. https://doi.org/10.3390/microorganisms11081989
APA StyleCao, X., Cai, J., Zhang, Y., Liu, C., Song, M., Xu, Q., Liu, Y., & Yan, H. (2023). Biodegradation of Uric Acid by Bacillus paramycoides-YC02. Microorganisms, 11(8), 1989. https://doi.org/10.3390/microorganisms11081989





